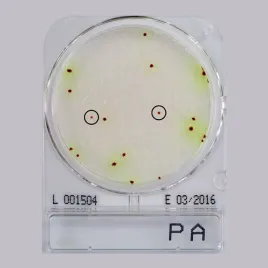

Pseudomonas aeruginosa — грамотрицательная, подвижная бактерия, широко распространённая в природе, включая воду, почву, воздух и на различных поверхностях. Является одним из наиболее устойчивых патогенов, часто встречающихся в медицинских учреждениях и вызывающих инфекции у пациентов с ослабленным иммунитетом.
Применяется как референтный штамм для:
- контроля микробной чистоты воды, воздуха и производственных поверхностей;
- валидации процессов дезинфекции и стерилизации;
- тестирования антимикробной устойчивости и эффективности дезинфицирующих средств.
Штаммы поставляются в стандартизированной форме, соответствуют международным требованиям к лабораторному контролю качества.
- Трипказо-соевый агар предназначен для выделения неприхотливых микроорганизмов, не имеющих специфических ростовых потребностей, и подсчета общего микробного числа при производстве нестерильных...06345
- Микроорганизм Инокулят (КОЕ) Результаты Рост Staphylococcus aureus ATCC 6538 10-100...10 шт. 02233
- Микроорганизм Инокулят (КОЕ) Результаты Рост Staphylococcus aureus ATCC 6538 10-100...10 шт. 02293
- Микроорганизм Инокулят (КОЕ) Результаты Рост Staphylococcus aureus ATCC 6538 10-100...10 шт. 06163
Контактная чашка Трипказо-соевый агар (TSA) с 4 нейтрализаторами и бета-лактаманаз (одинарный пакет)
Микроорганизм Инокулят (КОЕ) Результаты Рост Staphylococcus aureus ATCC 6538 10-100...10 шт. 06161- Питательная среда используется для количественного анализа чувствительности к антибиотикам быстро растущих аэробных и факультативно-анаэробных бактерий.В бульоне отрегулирована концентрация...01729
- Жидкость К для контроля стерильности сред Требования к хранению: 2 – 12 °C. Срок годности: 8 месяцев Требования к хранению: 2...01235
- Жидкость К для контроля стерильности сред Требования к хранению: 2 – 12 °C. Срок годности: 8 месяцев Требования к хранению...01221
- Забуференный раствор хлорида натрия рН 7,0 используется для приготовления суспензий микроорганизмов для тестирования стимулирующих рост и ингибирующих свойств сред при исследовании нестерильных...01212
- Триптиказо-соевый бульон для контроля стерильности на фармпроизводстве. Бульон для теста на стерильность TSB используется для проверки стерильности методом мембранной фильтрации или прямой инокуляции...01236
- Трипказо-соевый агар с лецитином, твином-80, гистидином и тиосульфатом натрия предназначен для выделения неприхотливых микроорганизмов, не имеющих специфических ростовых потребностей, и подсчета...06332
- Неингибированная среда, что позволяет легко восстановить микроорганизмы, богата питательными веществами, обеспечивает высокую скорость восстановления поврежденных клеток и усиливает рост...06327
- Неингибированная среда, что позволяет легко восстановить микроорганизмы, богата питательными веществами, обеспечивает высокую скорость восстановления поврежденных клеток и усиливает рост...06328
- Жидкость D (пептонная вода с полисорбатом 80) используется для разбавления или промывки образцов, содержащих лецитин или масло, при проведении тестов на стерильность. Требования к хранению: 2...01223
- Жидкость D (пептонная вода с полисорбатом 80) используется для разбавления или промывки образцов, содержащих лецитин или масло, при проведении тестов на стерильность. Требования к хранению: 2...01205
- Жидкость D (пептонная вода с полисорбатом 80) используется для разбавления или промывки образцов, содержащих лецитин или масло, при проведении тестов на стерильность. Требования к хранению: 2...01213
- Трипказо-соевый агар предназначен для выделения неприхотливых микроорганизмов, не имеющих специфических ростовых потребностей, и подсчета общего микробного числа при производстве нестерильных...06400
- Среда для серийных разведений при анализе нестерильных продуктов на микробную контаминацию. Требования к хранению: 2 – 12 °C. Срок годности: 6 месяцев Требования к...06310
- Универсальная жидкая питательная среда применяется для культивирования широкого спектра микроорганизмов, в том числе, требовательных к условиям роста. Требования к хранению: 2 – 12 °C....06309
- Забуференная пептонная вода служит средой первичного обогащения, которую используют для повышения высеваемости поврежденных сальмонелл из пищевых продуктов (перед селективным обогащением и выделением...01177
- Забуференный пептонный бульон с хлоридом натрия предназначен для разбавления образцов при анализе нестерильных продуктов на наличие микробных загрязнений. Данный раствор соответствует европейской...01171
- Забуференный пептонный бульон с хлоридом натрия предназначен для разбавления образцов при анализе нестерильных продуктов на наличие микробных загрязнений. Данный раствор соответствует европейской...01164
- Забуференный пептонный бульон с хлоридом натрия предназначен для разбавления образцов при анализе нестерильных продуктов на наличие микробных загрязнений. Требования к хранению: 2 – 12 °...01162
- Питательная среда для выделения неприхотливых микроорганизмов, не имеющих специфических ростовых потребностей. Данная среда соответствует агару В европейской фармакопеи, а также стандарту USP....01156
- Среда используется для обогащения аэробных бактерий, включая кишечную палочку, в косметических продуктах с консервантами или без них. Требования к хранению: 2 – 12 °C Срок годности:...01140
- Бульон предназначен для выделения неприхотливых микроорганизмов, не имеющих специфических ростовых потребностей, и подсчета общего микробного числа при производстве нестерильных фармацевтических и...01724
- Универсальная жидкая питательная среда применяется для культивирования широкого спектра микроорганизмов, в том числе, требовательных к условиям роста. ГОСТ 32031— 2022 Требования к...01722
- Среда используется для селективного обогащения микроорганизмов семейства Enterobacteriaceae в ходе санитарно-микробиологического исследования пищевых продуктов. Среда соответствует стандарту ИСО...01720
- Питательная среда, свободная от ингибиторов и индикаторов для широкого спектра задач. Соответствует рекомендациям Фармакопеи США – USP XXIII (1995) и Фармакопеи Европы – EP II. Богатая...01710
- Трипказо-соевый агар предназначен для выделения неприхотливых микроорганизмов, не имеющих специфических ростовых потребностей, и подсчета общего микробного числа при производстве нестерильных...01077
- Для культивирования и выделения облигатных и факультативных анаэробов и микроаэрофильных бактерий и теста на стерильность. Для определения эффективности санитарной обработки емкостей, поверхностей...01073
- Бульон предназначен для выделения неприхотливых микроорганизмов, не имеющих специфических ростовых потребностей, и подсчета общего микробного числа при производстве нестерильных фармацевтических и...01072
- Забуференная пептонная вода служит средой первичного обогащения, которую используют для повышения высеваемости поврежденных сальмонелл из пищевых продуктов (перед селективным обогащением и выделением...01054
- Универсальная жидкая питательная среда применяется для культивирования широкого спектра микроорганизмов, в том числе, требовательных к условиям роста. ГОСТ 32031— 2022...01039
- Универсальная жидкая питательная среда применяется для культивирования широкого спектра микроорганизмов, в том числе, требовательных к условиям роста.Лизин-железный агар рекомендуется для...01036
- Питательная среда рекомендуется для предположительной идентификации колиформ из различных образцов, таких как вода, молоко, продукты питания и клинические образцы. ...01024
- Универсальная жидкая питательная среда применяется для культивирования широкого спектра микроорганизмов, в том числе, требовательных к условиям роста. ...01018
- Питательная среда для первичной биохимической и морфологической идентификация колоний энтеробактерий в исследуемых образцах бактериологическим посевом в санитарной и клинической микробиологии....01015
- Высококачественная питательная среда, разработанная для тестирования чувствительности микроорганизмов к антимикробным средствам. ГОСТ Р 59786—2021 (ISO/TS 16782:2016, IDT) Требования к...01008
- Это комбинация свинцово-ацетатной среды, описанной Клиглером и Расселом, агаром с двойным сахаром, и используется в качестве среды для дифференциации брюшного тифа, дизентерии и родственных бацилл....01007
- Трёхслойная упаковка, асептический розлив с дополнительным гамма облучением. Добавление нейтрализующих агентов (Твин 80 - лецитин) может нейтрализовать различные дезинфицирующие средства. *...02099
- Трёхслойная упаковка, асептический розлив с дополнительным гамма облучением. Микробиологический контроль: Инкубировать при температуре 35°С±2 в течение 24-72 часов Tемпература...02089
- Трёхслойная упаковка, асептический розлив с дополнительным гамма облучением. Микробиологический контроль: Инкубировать в течение 3 дней при температуре 35±2 ºC и 5 дней при температуре...02047
- Трёхслойная упаковка, асептический розлив с дополнительным гамма облучением. Добавление нейтрализующих агентов TLHTh (Твин 80-лецитин - гистидин - тиосульфат натрия) может нейтрализовать различные...02116
- Трёхслойная упаковка, асептический розлив с дополнительным гамма облучением. Микробиологический контроль: Инкубировать 3 дня при 35±2 ºC и 5 дней при 25±2 ºC...02206
- Трёхслойная упаковка, асептический розлив с дополнительным гамма облучением. Добавление нейтрализующих агентов TLHTh (Твин 80-лецитин - гистидин - тиосульфат натрия) может нейтрализовать различные...02086
- Трёхслойная упаковка, асептический розлив с дополнительным гамма облучением. Микробиологический контроль: Инкубировать при температуре 35°С±2 в течение 24-48 часов Tемпература...02065
- Трёхслойная упаковка, асептический розлив с дополнительным гамма облучением. Микробиологический контроль: Инкубировать в течение 3 дней при температуре 35±2 ºC и 5 дней при температуре...02074
- Двухслойная упаковка, асептический розлив с дополнительным гамма облучением. Микробиологический контроль: Инкубировать при температуре 35°С±2 в течение 24-48 часов Tемпература...02087
- Двухслойная упаковка, асептический розлив с дополнительным гамма облучением. Рецептура основной среды приготовлена в соответствии с гармонизированным фармакопейным методом и стандартами ISO....02217
- Двухслойная упаковка, асептический розлив с дополнительным гамма облучением. Микробиологический контроль: Инкубировать при температуре 35°С±2 в течение 24-48 часов Tемпература...02118
- Двухслойная упаковка, асептический розлив с дополнительным гамма облучением. Микробиологический контроль: Инкубировать при температуре 35°С±2 в течение 24-48 часов Tемпература...02063
- Однослойная упаковка, асептический розлив Микробиологический контроль: Инкубировать при температуре 35°С±2 в течение 24-48 часов Tемпература хранения 2-12°С Срок хранения 4...02060
- Микроорганизм Инокулят (КОЕ) Результаты Рост Staphylococcus aureus ATCC 6538 10-100...10 шт. 06137
- Микроорганизм Инокулят (КОЕ) Результаты Рост Реакция Bacillus subtilis ATCC 6633...10 шт. 06133
- Микроорганизм Инокулят (КОЕ) Результаты Рост Staphylococcus aureus ATCC 6538 10-100...10 шт. 06125
- Микроорганизм Инокулят (КОЕ) Результаты Рост Реакция Bacillus subtilis ATCC 6633...10 шт. 06123
- Микроорганизм Инокулят (КОЕ) Результаты Рост Staphylococcus aureus ATCC 6538 10-100...10 шт. 06120
- Микроорганизм Инокулят (КОЕ) Результаты Рост Staphylococcus aureus ATCC 6538 10-100...10 шт. 06118
- Микроорганизм Инокулят (КОЕ) Результаты Рост Реакция Bacillus subtilis ATCC 6633...10 шт. 06116
- Tемпература хранения: c гамма облучением 2-25°С Срок хранения: c гамма облучением 5 месяцев Упаковка содержит 10 штук контактных чашек10 шт. 06150
- Микроорганизм Инокулят (КОЕ) Результаты Рост Реакция Bacillus subtilis ATCC 6633...10 шт. 06148
- Микроорганизм Инокулят (КОЕ) Результаты Рост Staphylococcus aureus ATCC 6538 10-100...10 шт. 06135
- Микроорганизм Инокулят (КОЕ) Результаты Рост Реакция Bacillus subtilis ATCC 6633...10 шт. 06139
- Микроорганизм Инокулят (КОЕ) Результаты Рост Реакция Bacillus subtilis ATCC 6633...10 шт. 06127
- Микроорганизм Инокулят (КОЕ) Результаты Рост Реакция Staphylococcus aureus ATCC 6538...10 шт. 06114
- Однослойная упаковка, предлагается в двух вариантах: асептический розлив или асептический розлив с дополнительным гамма облучением. Микробиологический контроль: Инкубировать при температуре 35...02091
- Однослойная упаковка, предлагается в двух вариантах: асептический розлив или асептический розлив с дополнительным гамма облучением. Микробиологический контроль: Инкубировать при температуре 35...02201
- Однослойная упаковка, предлагается в двух вариантах: асептический розлив или асептический розлив с дополнительным гамма облучением. Микробиологический контроль: Инкубировать при температуре 35...02048
- Однослойная упаковка, предлагается в двух вариантах: асептический розлив или асептический розлив с дополнительным гамма облучением. Добавление нейтрализующих агентов TLHTh (Твин 80-лецитин -...02135
- Однослойная упаковка, предлагается в двух вариантах: асептический розлив или асептический розлив с дополнительным гамма облучением. Добавление нейтрализующих агентов TLHTh (Твин 80-лецитин -...02151
- Однослойная упаковка, предлагается в двух вариантах: асептический розлив или асептический розлив с дополнительным гамма облучением. Рецептура основной среды приготовлена в соответствии с...02127
- R2А агар - это среда с низким содержанием питательных веществ; в сочетании с низкой температурой культивирования и длительным периодом инкубации данная среда особенно удобна для выявления...02110
- Цетримидный агар используется для селективного выделения и предварительной идентификации Pseudomonas aeruginosa из клинических и доклинических образцов. Микробиологический контроль:Инкубировать...02106
- Селективная дифференциальная среда для выявления и учета Е.coli и колиформных , Микробиологический контроль: Инкубировать при температуре 35±2 ºC в течение 24–48 ч...02109
- Глюкозосодержащая селективная среда для выявления и подсчета энтеробактерий в пищевых продуктах/ Микробиологический контроль:Культуральный ответ на агар VRBG при температуре 35°C ± 2...02111
- Забуференная пептонная вода служит средой первичного обогащения, которую используют для повышения высеваемости поврежденных сальмонелл из пищевых продуктов (перед селективным обогащением и выделением...01003
- Забуференная пептонная вода служит средой первичного обогащения, которую используют для повышения высеваемости поврежденных сальмонелл из пищевых продуктов (перед селективным обогащением и выделением...01101
- Универсальная жидкая питательная среда применяется для культивирования широкого спектра микроорганизмов, в том числе, требовательных к условиям роста. Требования к хранению: 2 – 12...01104
- Универсальная жидкая питательная среда применяется для культивирования широкого спектра микроорганизмов, в том числе, требовательных к условиям роста. Требования к...01107
- Среда для предварительного обогащения, которая используется перед селективным обогащением для выделения видов сальмонелл из пищевых продуктов. Комбинация лецитина, полисорбата 80, гистидина и...01109
- Питательная среда рекомендуется для предположительной идентификации колиформ из различных образцов, таких как вода, молоко, продукты питания и клинические образцы. Требования к хранению: 2...01111
- Забуференная пептонная вода служит средой первичного обогащения, которую используют для повышения высеваемости поврежденных сальмонелл из пищевых продуктов (перед селективным обогащением и выделением...01115
- Среда используется для селективного обогащения микроорганизмов семейства Enterobacteriaceae в ходе санитарно-микробиологического исследования пищевых продуктов Требования к хранению: 2 – 12...01118
- Забуференный раствор хлорида натрия рН 7,0 используется для приготовления суспензий микроорганизмов для тестирования стимулирующих рост и ингибирующих свойств сред при исследовании нестерильных...01119
- Забуференная пептонная вода служит средой первичного обогащения, которую используют для повышения высеваемости поврежденных сальмонелл из пищевых продуктов (перед селективным обогащением и выделением...01124
- Среда используется для селективного обогащения микроорганизмов семейства Enterobacteriaceae в ходе санитарно-микробиологического исследования пищевых продуктов. Среда соответствует стандарту ИСО...01127
- Забуференный раствор хлорида натрия рН 7,0 используется для приготовления суспензий микроорганизмов для тестирования стимулирующих рост и ингибирующих свойств сред при исследовании нестерильных...01128
- Забуференный раствор хлорида натрия рН 7,0 используется для приготовления суспензий микроорганизмов для тестирования стимулирующих рост и ингибирующих свойств сред при исследовании нестерильных...01131
- Забуференный раствор хлорида натрия с рН 7,0, в соотношении с Твином 80, является разбавителем, рекомендованным Гармонизированной Европейской фармакопеей для микробиологического исследования...01139
- Бульон рекомендуется для приготовления суспензии стабильного тестируемого штамма, используемой для подтверждения процедур микробиологического тестирования нестерильных продуктов. Для определения...01142
- Питательная среда для выделения неприхотливых микроорганизмов, не имеющих специфических ростовых потребностей. Данная среда соответствует агару В европейской фармакопеи, а также стандарту USP....01145
- Для обогащения аэробных бактерий, присутствующих в косметической продукции Бульон Эвгон рекомендован в качестве обогатительного бульона для увеличения микробной популяции. Данная среда...01146
- Селективная питательная среда для предварительного теста на присутствие E.coli, колиформных бактерий и определения E.coli или колиформных бактерий в молоке, в воде и других объектах по...01151
- Трипказо-соевый бульон с лецитином, твином-20, предназначен для выделения неприхотливых микроорганизмов, не имеющих специфических ростовых потребностей, и подсчета общего микробного числа при...01154
- Триптиказо-соевый бульон для контроля стерильности на фармпроизводстве. Бульон для теста на стерильность TSB используется для проверки стерильности методом мембранной фильтрации или прямой инокуляции...01200
- Рекомендуется для быстрого культивирования аэробов, а также анаэробов, включая микроаэрофилы, для проверки стерильности антибиотиков, биологических препаратов и продуктов питания. Глюкоза, пептон и...01202
- Рекомендуется для быстрого культивирования аэробов, а также анаэробов, включая микроаэрофилы, для проверки стерильности антибиотиков, биологических препаратов и продуктов питания. Глюкоза, пептон и...01206
- Жидкость D (пептонная вода с полисорбатом 80) используется для разбавления или промывки образцов, содержащих лецитин или масло, при проведении тестов на стерильность. Требования к хранению: 2...01207
- Триптиказо-соевый бульон для контроля стерильности на фармпроизводстве. Бульон для теста на стерильность TSB используется для проверки стерильности методом мембранной фильтрации или прямой инокуляции...01210
- Жидкость D (пептонная вода с полисорбатом 80) используется для разбавления или промывки образцов, содержащих лецитин или масло, при проведении тестов на стерильность. Требования к хранению: 2...01222
- Трипказо-соевый агар предназначен для выделения неприхотливых микроорганизмов, не имеющих специфических ростовых потребностей, и подсчета общего микробного числа при производстве нестерильных...06304
- Готовая питательная среда «Агар R2A» предназначена для подсчета общего количества аэробных микроорганизмов в очищенной воде при проведении микробиологического исследования. Требования...06306
- Трипказо-соевый агар предназначен для выделения неприхотливых микроорганизмов, не имеющих специфических ростовых потребностей, и подсчета общего микробного числа при производстве нестерильных...06308
- Микроорганизм Инокулят (КОЕ) Результаты Рост Реакция Bacillus subtilis ATCC 6633...10 шт. 06132
- Микроорганизм Инокулят (КОЕ) Результаты Рост Реакция Bacillus subtilis ATCC 6633...10 шт. 06102
- Микроорганизм Инокулят (КОЕ) Результаты Рост Реакция Bacillus subtilis ATCC 6633...10 шт. 06104
- Микроорганизм Инокулят (КОЕ) Результаты Рост Реакция Bacillus subtilis ATCC 6633...10 шт. 06134
- Tемпература хранения 2-12°С Срок хранения 4 месяца02051
- Микробиологический контроль: при температуре 35± 2° C в течение 24–48 часов Tемпература хранения 2-12°С Срок хранения 4 месяца10 шт. 02093
- Сторона 1: Трипказо-соевый агар Сторона 2: Агар Сабуро с декстрозой Микробиологический контроль: Инкубировать при температуре 35±2 ºC в течение 24 часов и при температуре 25...20 шт. 06017
- Сторона 1: Хромагар для Золотистого стафилококка Сторона 2: Хромагар Псевдомонады Микробиологический контроль: Инкубировать при 35±2°C в течение 24 часов и при 30±2...20 шт. 06041
- Сторона 1/2: Агар с желчью и фиолетовым красным Микробиологический контроль: Инкубировать при температуре 35±2 ºC 18-24 часа. Tемпература хранения: 8-20°С20 шт. 06044
- Сторона 1: Агар R2A Сторона 2: Хромогенный агар для подсчета и обнаружения кишечной палочки и колиформных бактерий. Tемпература хранения: 8-20°С20 шт. 06055
- Сторона 1: Агар для определения микробного числа c нейтрализатором + TTC Сторона 2: Хромогенный псевдомонадный агар Микробиологический контроль: Инкубировать при температуре 35...20 шт. 06056
- Сторона 1: Трипказо-соевый агар с 4 нейтрализаторами Сторона 2: Агар с бенгальским розовым, дихлораном и хлорамфениколом Tемпература хранения: 8-20°С20 шт. 06060
- Цетримидный агар используется для идентификации Pseudomonas aeruginosa в клинических и доклинических образцах. Микробиологический контроль: Инкубировать при температуре 35± 2° C в течение 24-48...02005
- Подложки синегнойная палочка - Compact Dry PА Готовая к использованию сухая хромогенная среда для идентификации Синегнойная палочка (Pseudomonas Aeruginosa). Синегнойная палочка (Pseudomonas...4 шт.